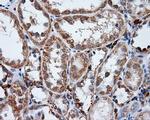
LIPG Antibody in Immunohistochemistry (Paraffin) (IHC (P))

Search
OriGene
LIPG Monoclonal Antibody (OTI9F2), TrueMAB™
{{$productOrderCtrl.translations['antibody.pdp.commerceCard.promotion.promotions']}}
{{$productOrderCtrl.translations['antibody.pdp.commerceCard.promotion.viewpromo']}}
{{$productOrderCtrl.translations['antibody.pdp.commerceCard.promotion.promocode']}}: {{promo.promoCode}} {{promo.promoTitle}} {{promo.promoDescription}}. {{$productOrderCtrl.translations['antibody.pdp.commerceCard.promotion.learnmore']}}
产品信息
TA501019
种属反应
宿主/亚型
分类
类型
克隆号
抗原
偶联物
形式
浓度
纯化类型
保存液
内含物
保存条件
运输条件
靶标信息
LIPG (Lipase G, Endohelial type) is an endothelial lipase which is a novel member of the lipoprotein lipase gene family. LIPG is synthesized by endothelial cells and functions at the site of synthesis. LIPG most likely plays a physiological role in modulating lipoprotein metabolism. Overexpressed LIPG has been shown to reduce HDL cholesterol levels, whereas an LIPG deficiency appears to be effective in elevating HDL cholesterol levels in animals. LIPG has substantial phospholipase activity and may be involved in lipoprotein metabolism and vascular biology. Also, LIPG is designated a member of the TG lipase family by its sequence and characteristic lid region which provides substrate specificity for enzymes of the TG lipase family. LIPG is a carboxyl esterase that hydrolyzes high density lipoproteins, emulsifies triglycerides, is essential for the efficient digestion of dietary fats and can bind to heparin.
仅用于科研。不用于诊断过程。未经明确授权不得转售。
篇参考文献 (0)
生物信息学
蛋白别名: EDL; Endothelial cell-derived lipase; Endothelial lipase; lipase, endothelial; lipoprotein lipase H; Phospholipase A1; PL
基因别名: EDL; EL; LIPG; PRO719; UNQ387/PRO719
UniProt ID: (Human) Q9Y5X9
Entrez Gene ID: (Human) 9388